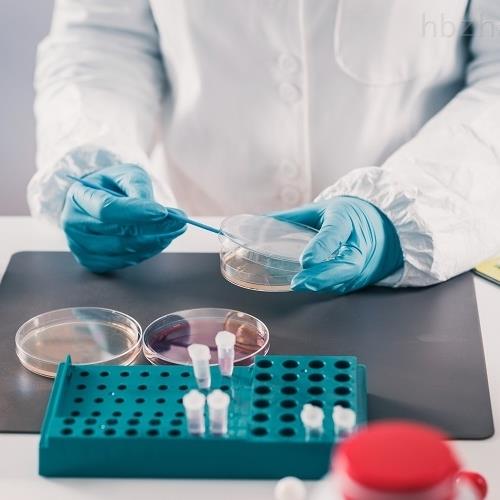
638344493827053226753.jpg

2026年01月14日 09:15:33 来源:中科检测技术服务(广州)股份有限公司 >> 进入该公司展台 阅读量:5
学校办公设备类资产报废主要包括:计算机、打印机、复印机、传真机、办公家具等。学校办公设备资产报废的原因可能包括设备老化、损坏、功能落后等。
学校办公设备固定资产报废是指经科学鉴定或按有关规定,已不能继续使用,必须进行产权注销的资产处理。固定资产报废多因超过使用年限、结构陈旧、缺套残损、精度丧失或下降、性能低劣等。
作为国科控股旗下独立第三方鉴定机构,中科检测具有固定资产报废鉴定资质,可根据委托方提供的拟报废评估资产清单及相关资料,组织技术人员对拟报废评估的资产进行评估,出具学校办公设备报废鉴定评估报告。
学校办公设备报废鉴定报废条件
1.已超过资产使用年限;
2.无法正常使用、无法满足现有工作使用需求,失去使用、修复价值,继续使用会产生危险或安全隐患,并经论证需要报废、淘汰的资产。
学校办公设备报废鉴定方法
1.收集资产信息:了解资产的类型、规格、制造商、日期、使用时间以及过往的维护记录等信息。
2.检查资产的物理状况:检查资产的外观是否完好,是否存在磨损、裂纹、变形等问题。观察是否有部件损坏、锈蚀或缺失情况。
3.进行功能检测:对资产的各项功能进行测试,确保其是否能正常工作。这包括启动设备、测试连接性、检查电池或电源的运行状况以及进行必要的调试。
4.进行性能评估:使用适当的测试工具和软件,评估资产的性能水平。例如,对于计算机设备,可以运行基准测试以评估处理器速度、内存容量和硬盘性能等。
5.分析维修和维护成本:考虑到资产的维护和修理成本,与购买全新设备的成本进行对比。如果维修费用显著高于购买新设备的费用,则可能推荐报废。
6.参考标准和规定:根据相关的标准和规定,例如制造方建议的期限或保修期限,考虑资产是否已经超过预定的使用期限。
学校办公设备报废鉴定案例
为进一步加强学校资产报废处置管理,规范国有资产处置行为,防止资产流失,根据、有关文件规定和学校国有资产管理相关要求,某校开展XXXX年度资产报废处置工作,主要针对一批到达使用年限的的办公设备、专用设备及家具用具,为确定该批设备是否达到报废状态,大学委托本司对该批设备是否达到报废状态进行鉴定。
鉴定分析结果:
鉴定分析专家组对委托鉴定评估的设备进行了现场检验和查勘结果,作出以下建议和结论:
该批设备中有156件已无法满足使用需求且存在安全隐患,建议报废。
学校办公设备报废鉴定流程
1、初步审核;鉴定前,需要审核鉴定目的是否合理合规,是否具备鉴定条件等,初步确定是否能做。
2、材料整理;确定可以受理,这时需要提供如固资清单,标的参考图片等材料。用以核算鉴定费用及周期。
3、费用报价,收到材料后,我机构会组织技术部门核算鉴定费,一般时长为一到两个工作日,核算后出具正式报价函。
4、签定协议;报价函出具后,报相关部门审批,待批复后,签定技术服务协议,进入鉴定费支付环节。
5、现场勘察;我机构收到鉴定费后,1——5个工作日内安排技术人员及专家现场勘验,勘验结束后,技术根据材料做调查分析,并编写报告。
6、出具报告;报告出具需要时长大约10——20个工作日,报告初稿形成后,再经过一审、二审、终审,最终出具鉴定报告。此时根据委托方需求来拟定报告的份数,并附发票一起邮寄给委托方。委托方收到报告后之日起15日内,若有任何异议请回复我机构,我机构会组织技术人员及专家对鉴定报告进行复核并作出答复,超过时间未收到回复的,我机构默认相关当事人和委托人均认可鉴定报告中涉及相关内容。